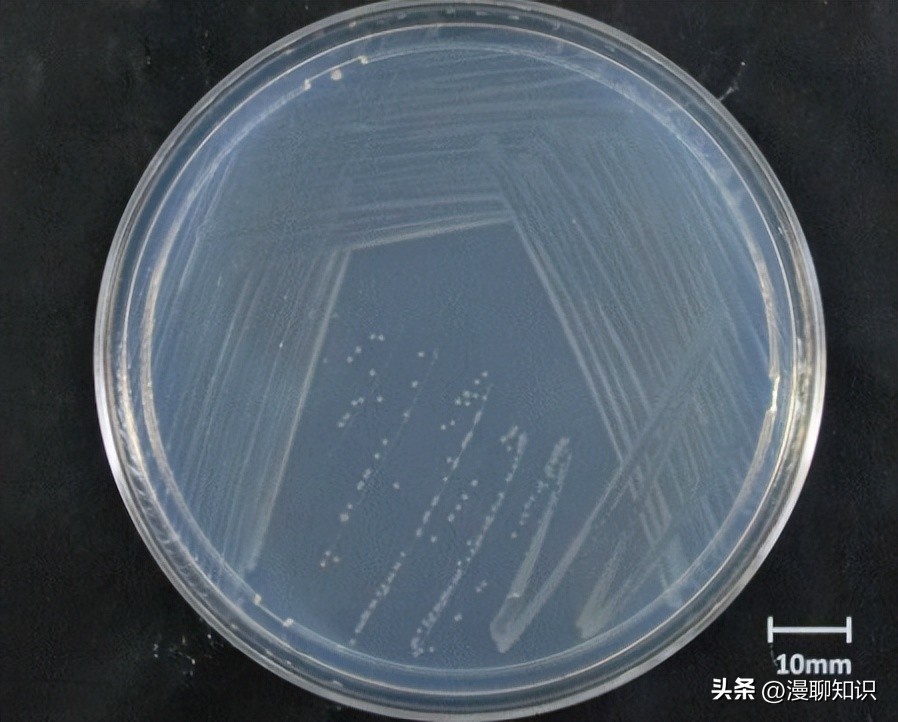
高效脱氮菌种,高效脱氮菌
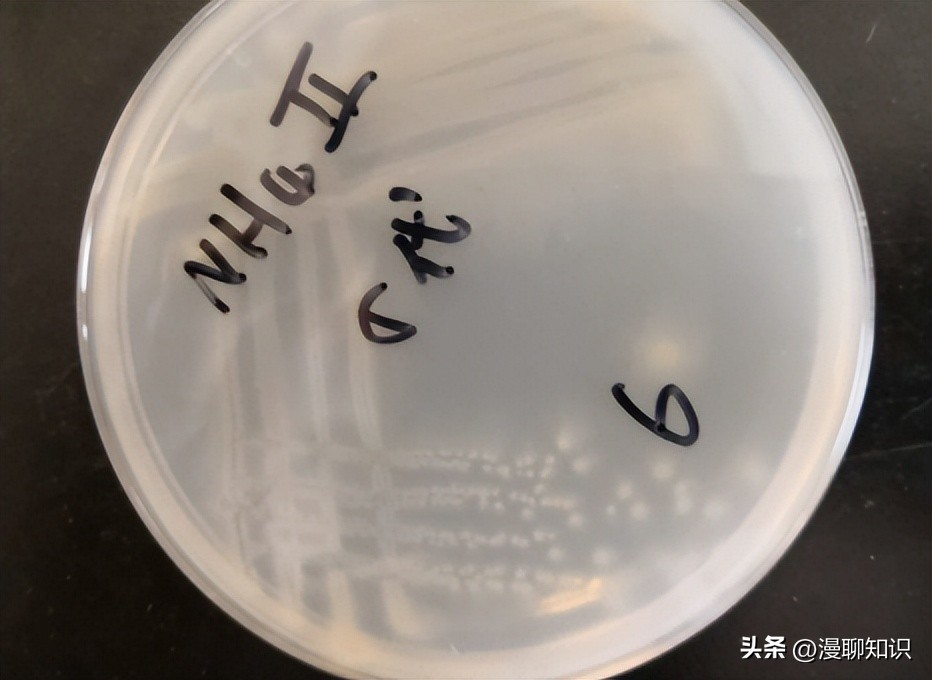
高效脱氮菌种,高效脱氮菌

阅读文章前,辛苦您点下右上角的“关注”,方便您讨论分享,持续关注每日优质内容~
随着我国农村生活水平的提高,饮食结构发生了变化,农村生活污水含碳量减少,出现低碳氮比(C/N比)的情况。
由于碳源不足,脱氮效率降低,污水排入河流中使藻类大量繁殖影响水质进而危及人民健康。
土壤渗滤系统作为处理农村生活污水常用的工艺,强化了土壤微生物和植物的净化性能,通过物理、化学及生物作用净化污水。
然而对于低温和低C/N的生活污水,其温度及营养比均不利于细菌生长,为了使微生物能够更好地适应并处理低温低C/N比的生活污水,对微生物的驯化是必要的。
本文从应用于北方的污水地下渗滤系统中筛选出高效脱氮菌,并对其进行低温、低C/N驯化;然后将驯化后的菌株应用到实验室小型模拟土壤渗滤系统中。

材料与方法
实验材料
材料
模拟生活污水的配制:以CH3COOH为碳源,(NH4)2SO4为氮源,KH2PO4为磷源,每升水中投加1.2 mL微量元素,采用自然pH。
在低C/N比驯化过程中,总磷(TP)浓度为5 mg/L,氨氮(NH3-N)浓度为25 mg/L。
按照25 mg/L的NH3-N为基准,配置污水中的生化需氧量(COD)的浓度。
举例说明,当C/N=20∶1和7∶1时,NH3-N质量浓度均为25 mg/L,COD质量浓度分别为500 mg/L和175 mg/L。
微量元素:0.2 g/L FeSO4·7H2O、1 g/L CoCl2·7H2O、0.8 g/L Na2MoO4·7H2O、0.2 g/L CaCl2,pH值为7.2。
牛肉膏蛋白胨培养基:3 g/L牛肉膏、10 g/L蛋白胨、5 g/L NaCl、15~20 g/L琼脂,pH值为7.4~7.6。
土壤:实验土壤采用草炭土,购自沈阳南湖花鸟鱼市场。

实验装置
土壤渗滤系统小试装置采用有机玻璃材质制备,反应器内径为8.7 cm,高为35.0 cm,有效容积为2 L。
污水通过蠕动泵经顶端进水,经反应器底部直径为2.0 cm的排水阀排出。
其中进水管和出水管由直径为2~3 cm砾石包裹,防治堵塞。
实验方法
高效脱氮菌株的分离与筛选
取运行稳定的处理农村生活污水的土壤渗滤系统的中层土壤于无菌水中,振荡溶解后静置。
取1 mL上清液于装有9 mL无菌水的无菌离心管中,获得10-1的菌液,以此类推,获得10-2~10-6不同浓度梯度的菌液。
采用稀释平板涂布法分离菌株,在无菌操作台里将不同浓度菌液接种于固体牛肉膏蛋白胨培养基上,在30℃的恒温生化培养箱中培养12~24 h。
将活化过的单菌落菌株接种在装有150 mL模拟生活污水(C/N=20∶1)的锥形瓶中,根据不同菌株对生活污水的处理效率,筛选去除率高的菌株进行鉴定。
驯化实验
驯化实验包括低C/N比驯化、低温驯化、低温对低C/N比驯化的影响以及驯化菌种的应用。
低温驯化是在装有150 mL C/N=20∶1的生活污水的锥形瓶中,以5%的接种量接入对数生长期的PM3和PM7,在30℃、150 r/min恒温振荡培养箱中培养48 h,测定OD600、NH3-N及COD浓度,并计算处理效率。
48 h后再次接种入新的生活污水中,当NH3-N及COD去除率趋于稳定时降低恒温振荡培养箱温度至25、20、15、10℃。
低C/N比驯化部分是在低温驯化的基础上进行,应用经低温驯化过的PM3和PM7,10℃下进行低C/N比驯化,驯化过程同上。
驯化的初始C/N比为20∶1,分别降低为15∶1、13∶1、10∶1。
低温对低C/N比的驯化影响是将完成低温驯化的PM3和PM7时,分别以10℃和30℃的温度条件进行低C/N比驯化。
以各C/N比梯度驯化的最后一代为参照,比较不同温度对驯化所消耗时间的影响,以此来研究低温对低C/N比驯化的影响。
其中:P0表示初始生活污水中NH3-N和COD质量浓度(mg/L);Pt表示时间t时生活污水中NH3-N和COD浓度(mg/L)。
驯化菌种的应用
设置一个对照和两个土壤中添加菌株的处理:1#对照(不加菌);2#驯化后的细菌(PM3∶PM7=1∶1)与草炭土以1∶9体积比混合均匀;3#未驯化的原代细菌(PM3∶PM7=1∶1)与草炭土以1∶9体积比混合均匀,填充于有机玻璃土柱中压实,实验室温度保持10~15℃,使用蠕动泵(BT100-2J,河北,中国)进水,进水C/N=7∶1水力负荷为0。
2 m3/(m2·d),稳定运行28 d,在干湿比为1∶1的条件下测定出水NH3-N、总氮(TN)的去除率。

分析方法
检测方法
NH3-N和COD的测定采用国标法,分别为《水质氨氮测定纳氏试剂分光光度法(HJ 535-2009)》和《水质化学需氧量的测定快速消解分光光度法(HJ/T 399-2007)》。
TN的测定根据《水和废水监测分析方法(第四版)》,采用过硫酸钾氧化—紫外分光光度法。
OD600使用紫外-可见分光光度计,以去离子水做参比,在600 nm波长下测定。

菌株鉴定
将纯化的菌株送至生工生物工程(上海)股份有限公司进行测序。
菌株采用16S rRNA鉴定,通过细菌基因组DNA提取、16 S rDNA特异引物PCR扩增、扩增产物纯化、DNA测序、序列比对等步骤对菌株进行鉴定。
数据分析
采用Excel2019软件整理试验数据,利用Origin Pro2018软件作图。

实验结果与讨论
高效脱氮菌株的筛选与鉴定
分离纯化后获得了11株不同菌株,其编号分别为PM1~PM11。
11株菌株均在24~48 h左右达到最低NH3-N浓度,其中PM1、PM3、PM4、PM6和PM7在48 h浓度低于1 mg/L。
尤其是PM3可在12 h达到最佳NH3-N处理效果,且在活化实验中观察PM3和PM7的生长速率最快,生物量最高。
因此,选择PM3和PM7为筛选出的高效脱氮菌,并对其进行16S rRNA鉴定。
菌株的鉴定结果为PM3和PM7分别为Acidovorax和Lysinibacillus fusiformis。

低温驯化
由结果可知,在培养驯化初期(1~13 d),当温度条件改变时,细菌的OD600值及对NH3-N、COD的去除率波动明显,但在各阶段第2批迅速恢复,而后逐渐上升。
在16 d温度降为15℃时,两种细菌的OD600值及NH3-N、COD去除率发生了断崖式下降,而后缓慢上升。
由微生物原理可知,温度在低于15℃时,微生物活性下降,低于10℃活性会明显下降,因此温度对PM3、PM7两种菌株的生长繁殖及其对NH3-N、COD的去除效果影响较大。
对应在第23 d温度降低至10℃时比上一温度阶段15℃OD600及NH3-N、COD的去除率明显下降且降至最低,经过培养缓慢回升且趋于平稳,PM3及PM7的OD600值分别稳定在0.285和0.283;NH3-N去除率分别稳定在52.19%和49.63%;COD的去除率分别稳定在51.13%和51.24%。
两种菌株在低温的条件下对污水NH3-N的处理效率由初期的不足5%提高到了50%以上。

由实验结果可知,在低温培养驯化的过程中PM3和PM7的OD600及对污染物的去除效率的变化趋势相似,然而在改变温度条件时,PM7的变化幅度相对较小,可见PM7对于不利环境有一定的适应能力。
PM7为芽孢杆菌属,努斯热提古丽等[9]研究了芽孢杆菌属的生物学特性,该菌属能够在不利条件下产生具有抵抗能力的芽孢来保护自身不受侵害。
虚线表示延长10℃最后一批菌株生长时间2 h(8 h增至10 h)后测定的OD600、NH3-N和COD去除率,三者均有明显增加。
PM3和PM7的OD600分别由0.284升至0.472和由0.282升至0.423;PM3和PM7的NH3-N去除率分别由51.97%升至80.39%和50.05%升至67.43%;PM3和PM7的COD去除率分别由50.57%升至82.20%和由49.24%升至75.4%。
这是由于在低温条件下微生物的新陈代谢活动仍在进行,但速度减缓,因此对NH3-N及COD的去除率较低,然而适当延长培养时间亦会得到良好的去除效果。

低C/N比驯化
从实验结果可看出,在驯化前期(1~5 d),改变C/N比时,2种菌株的OD600值急剧下降,说明进水污水COD的突然改变对细菌的影响很大,可直接干扰其正常生长。
PM3和PM7在改变C/N比的过程中OD600的变化趋势大致相同,均为在不同的C/N比阶段中OD600值处于上升的趋势,说明在驯化过程中细菌逐渐适应了此阶段低C/N比的环境,开始大量增殖,对细菌活性的提高起到了关键作用。
适应此阶段C/N比后,待OD600值及NH3-N、COD的去除率趋于稳定进行下一阶段C/N比的驯化。
两种菌株在低C/N比的条件下对污水NH3-N的处理效率由驯化前的不足5%提高到了30%以上。

总体来看,C/N比的改变对COD的去除影响较小,对NH3-N的去除率影响较大。
在最佳C/N比(20∶1)的情况下,2种菌株生长最好,对COD的去除效率均稳定在98%左右,NH3-N的去除率也在95%以上,改变C/N比后,COD去除率虽有下降但也稳定在90%以上,然而NH3-N的去除率急剧下降,PM3由95.32%降至48.87%,PM7由96.57%降至50.75%,说明两种菌株NH3-N的去除率对C/N比的改变有较高的灵敏度。
驯化中期(5~25 d),NH3-N的去除效果与OD600值的变化趋势大致相同,均为在不同C/N比阶段中先下降后上升,说明OD600值对NH3-N的去除起到了主要作用。
其中当C/N比由13∶1变为10∶1时,OD600值下降不明显,但NH3-N及COD初始阶段有较明显下降,这与Choi的实验结果相一致,只有在C/N>10时,对氮有较好的去除效果。
驯化后期(26~32 d),当C/N比由10∶1变为7∶1时,OD600值下降不明显,然而NH3-N及COD的去除率发生明显下降,这是由于污水中碳源较少,细菌对碳利用不足,导致活性下降,脱氮效率较低。

低温对低C/N比驯化的影响
为探究低温条件对低C/N比驯化的影响,实验中对进水COD浓度进行了调整控制,进一步研究了当在10℃条件下,不同C/N比的条件下,COD和TN的去除率与30℃时各污染物去除率达到一致时所消耗的时间。
由实验结果可知,在相同的C/N条件下,当污染物的去除率相同时,10℃比30℃耗时平均长4。
5 h。
因为随着温度的降低,微生物细胞内的酶的活性也随之下降,使得物质代谢过程中各种生化反应速度减慢,因此对于相同浓度的污染物来说,去除时间相对较长。

驯化菌种的应用
污水中的氮素主要通过土壤物理吸附、生物转化及氨氮的挥发等过程去除,其中生物转化是脱氮的主要途径。
土壤渗滤系统主要通过NH3-N挥发作用和硝化反应和NO3-N反硝化反应来实现对氮素的去除。
添加菌剂的反应器(1#及3#)的NH3-N去除率明显高于未添加菌剂的反应器(1#)。
启动前期(2~10 d)NH3-N及TN的去除效果并不理想但持续升高,这是因为系统在启动初期土壤中的微生物处于生长发育阶段,当污水流经土壤时,微生物吸附污水中的营养物质,将其氧化分解,微生物不断繁殖。

10 d时三个反应器中NH3-N和TN的去除效率持续升高,2#反应器NH3-N和TN去除率分别为34.31%和25.58%;3#反应器NH3-N和TN去除率分别为33.18%和22.49%,较1#反应器的NH3-N和TN去除率有明显提高。
这是由于微生物的繁殖,土壤内的有机物逐渐减少,限制了异养菌的生长,硝化菌逐渐增加的结果。
14~28 d期间,系统进入稳定期,3个反应器均对NH3-N的去除率趋于稳定,TN的去除率增高速度减缓,因为NO3-N含量减少使TN含量下降。
此阶段1#、2#、3#反应器NH3-N的平均去除率为分别为43.55%、57.36%、52.20%,TN的平均去除效率分别为31.98%、51.48%及43.36%。
2#、3#反应器NH3-N和TN的去除率均比1#反应器高,可见添加微生物菌剂可以提高土壤渗滤系统对氮素的去除率。
整个实验阶段,2#反应器对NH3-N和TN的去除率均高于3#反应器,且稳定性良好,这是因为2#反应器中添加的经过低温和低C/N驯化的菌剂活性较强[17],适应了低温和低C/N进水的环境,系统硝化作用良好,因此对NH3-N和TN具有良好的处理效果。

综上所述,可得如下4个结论:
1)在C/N比为7∶1的条件下,两种菌株经过驯化可获得较好的除污能力,对COD的去除率均在90%以上,对NH3-N的去除率在30%以上。
2)两种菌株在10℃条件下驯化培养后能较好的适应低温环境,并保持良好的活性。
经驯化后两种菌株对COD的去除效率均在50%以上,对NH3-N的去除率均在45%以上。
3)由低温对低C/N比驯化的影响实验得出,在相同的C/N条件下,当污染物的去除率相同时,10℃比30℃耗时平均长4。
5 h。
4)在相同的进水条件下,反应器1#,2#,3#分别表现出不同的除污能力,以氮素去除率作为标准,除污能力由高到低依次为2#>3#>1#,验证了在低温环境和低C/N进水条件下,添加经低温和低C/N驯化的脱氮菌株会增强土壤渗滤系统的脱氮性能。
《农村生活污水治理的技术及对策探讨》
《农村生活污水处理技术研究进展及改进设想》
《藻菌比对低碳氮生活污水处理效能的影响》